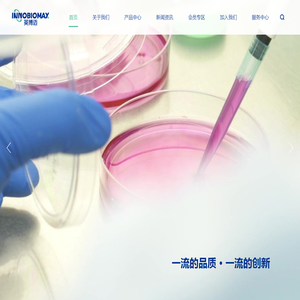
厦门英博迈生物科技有限公司

以下是关于搜索 NTC 相关网站的结果共有 30 条,当前显示最新 30 条结果。


由江苏省复合材料学会主办、江苏大秦国际展览有限公司负责承办的“2026中国(苏州)国际高性能复合材料展览会”(简称:CSCME苏州国际复材展)将于2026年5月27-29日在苏州国际博览中心隆重举办!
更新时间:2025-12-18 直链:www.cscmexpo.com

英文缩写网收集了50万余的英文缩写,提供最新英文缩写大全和缩略词查询和缩略词及其意思和解释,包括月份的英文缩写,有限公司英文缩写等绝大多数常见英语缩略词。
更新时间:2025-12-18 直链:www.enabbr.net

中山市泰铭五金有限公司专注于生产组合螺丝,高强度螺钉,自攻螺丝,螺钉定制,优选泰铭五金螺丝生产厂家,可根据用户要求生产各种螺钉,批量生产螺钉.
更新时间:2025-12-18 直链:www.taimingcn.com

永辉盛是国内道康宁硅胶(陶氏)一级代理商,专注特种硅胶原材料15年,自陶氏收购道康宁公司后,道康宁硅胶正式改名陶熙硅胶,我司可提供硅胶材料(有机硅材料、硅橡胶材料)各种解技术解决方案。
更新时间:2025-12-18 直链:www.ddguijiao.com

【广东煌盛体育设施有限公司】是一家专业的塑胶跑道生产厂家,主要提供塑胶跑道,运动场材料厂家,篮球场材料,学校塑胶跑道,混合型塑胶跑道,透气型塑胶跑道,塑胶球场等,集生产,研发,设计,施工,中国塑胶跑道十大厂家之一。
更新时间:2025-12-17 直链:www.tiyudiping.com

福建爱邦电器有限公司成立于2010年1月,位于福鼎市文渡工业区,注册资本金:2000万元,占地面积29743平方米,厂区建筑面积44780平方米,前身为瑞安市爱邦电器有限公司,创办于1991年。本公司是一家集科工贸于一体的综合企业。 本公司专业生产汽车、摩托车、电气线路的各种接插件、保险盒、保险片、线束、灯座等,与全国各地几十家汽车合作配套。
更新时间:2025-12-17 直链:www.iiib.biz


唐山市开平区金文建材有限公司位于唐山市开平区205国道后营村西(距京沈高速唐山东出口2公里),是一家集研发、制造于一体的中型民营企业,占地面积20亩。主导产品为园林景观砖、市政铺道砖、建筑用烧结砖、焦炉用耐酸缸砖、保温砖等新型优质环保产品,年生产能力12万平米。
更新时间:2025-12-17 直链:www.tsbrick.cn

肇庆爱晟传感器技术有限公司是专业生产及销售定制型高精度NTC温度传感器,高灵敏温度传感器,高可靠NTC热敏电阻、玻璃封装热敏电阻等热敏电阻元器件生产厂家,我们不断努力为客户制造出高品质的NTC温度传感器热敏电阻和定制化的服务!
更新时间:2025-12-17 直链:www.exsense.net


湖南省三联磁电设备有限公司是一家致力于大型管道消磁技术和智能充磁技术的高科技公司,公司主要研发和生产管道消磁机,脉冲充磁机,脉冲退磁机。设备广泛用于各种石油管道、热电管道、供水管道等施工现场的消磁,以及马达,音响扬声器,风力发电机等生产现场的充磁、退磁。
更新时间:2025-12-17 直链:www.ldcd.net

苏州龙阳纸箱供应:(苏州,吴江,吴中,园区,苏州园区)纸箱,苏州纸箱厂,苏州纸箱厂家,吴江纸箱厂,吴中纸箱厂,吴中瓦楞纸箱,吴江瓦楞纸箱,吴江纸箱厂家,服务热线:15062528006
更新时间:2025-12-17 直链:www.szlybz.cn

衡水蓬泽钢结构工程有限公司主营照明灯塔,升降式投光灯塔(照明灯塔),高杆灯塔,瞭望塔,森林防火瞭望塔,监控瞭望塔,边防执勤瞭望塔,消防训练塔,电视塔,电视发射塔,电视转播塔等多种塔类,欢迎广大客户前来订购,订购电话:18232975678。
更新时间:2025-12-17 直链:www.zxtieta.net


重庆网站建设公司-专业从事重庆网站建设,企业营销型网站建设,网站制作,网站改版,手机网站制作,微站建设,网站优化,网站推广的上海网络公司.专业技术团队竭力真诚服务!
更新时间:2025-12-17 直链:www.chongqing114.cn

北京市惠诚(青岛)律师事务所,系在惠诚总所和青岛市市区两级司法局的支持关怀下,新近成立的极具发展潜力的特色律师事务所,本所在企业合规管理,法律产品研发,资本市场,知识产权,公司事务,破产管理,婚姻家事,交通保险,劳动争议,刑事辩护,刑民交叉业务领域具有突出优势,北京市惠诚律师事务所系1998年成立,秉承
更新时间:2025-12-17 直链:www.huichengqingdao.com

济宁柯迪纸制品有限公司是一家深受欢迎的济宁纸箱厂家,主营纸箱包装,纸箱定做,生产各种规格高,中,低档瓦楞纸箱,异形纸箱纸盒,展示盒,彩印纸箱,彩盒等纸制品,欢迎广大客户前来业务咨询
更新时间:2025-12-17 直链:www.kdzxbz.com

广东东远跨境供应链管理有限公司专业的美国自营仓库海外仓公司,专注为物流和跨境电商提供可查询的一件代发,FBA退货换标,中转补仓,尾程转运等一站式海外仓储智能配套服务,服务热线:13929215508.
更新时间:2025-12-16 直链:www.ff-supplychain.com


一个随缘更新的小站,记录老路同学和瑞瑞的一个可分享信息,采集和手动分享一些手游源码、红包活动、免费会员等各种撸羊毛信息,希望能帮助到你。_老路同学_分享一些手游源码、红包活动、免费会员等各种撸羊毛信息
更新时间:2025-12-16 直链:www.80jc.com


源壹科技(东莞)有限公司是一家集冷却塔、立式管道泵、专用电机的研发、生产、销售为一体的生产厂家,产品包括:玻璃钢开式冷却塔、闭式冷却塔、污水冷却塔、冷冻泵/管道泵以及冷却塔配件等。产品广泛应用于电力、冶金、化工、制药、造纸、纺织印染、民用空调等行业。
更新时间:2025-12-16 直链:www.yuanone.com.cn

嘉兴市凯斯设备制造有限公司是一家专业不锈钢类机械设备的设计、生产的企业。公司依托大专院校、科研机构的战略联盟及多年的研发经验,汇聚了优秀的机械制造、工艺设计及自动控制人才,公司产品博采众长,不断完善,具有专业、耐用、美观、智能高效的优点,畅销国内,远销美国、日本及东南亚国家。欢迎新老客户前来洽谈!
更新时间:2025-12-16 直链:www.kase.cn

成都西夏科技发展有限公司长期从事微波、毫米波技术领域精密机械零部件的设计、加工。我司为国内多家科研机构、重点院校提供微波腔体的设计及精密加工服务。
更新时间:2025-12-16 直链:www.xixiakeji.com

潍坊隆昌机电科技有限公司提供振动给料机、永磁滚筒、电子皮带称、定量给料机、电磁除铁器、大倾角皮带机、自卸式除铁器、自动配料系统、对辊破碎机、废钢磁选机等机电设备,并给客户提供技术培训,安装调试等服务。
更新时间:2025-12-16 直链:www.sdxieli.cn

上海莱禾机电科技有限公司是一家专注于无油真空泵及旋片式真空泵的高新技术企业;对真空泵及真空系统方面有着丰富的经验,可以为客户提供理想并完善的真空解决方案。莱诺服务热线:4006-112-722
更新时间:2025-12-16 直链:www.reohe.com